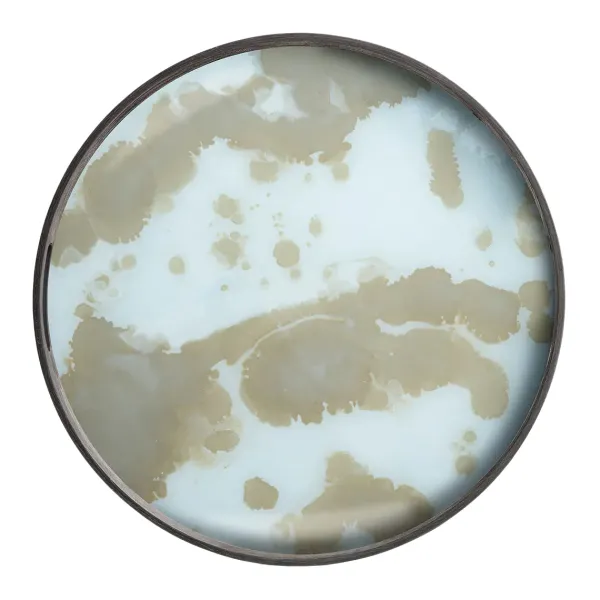
Plateau - Mist Gold Organic - O 48 Cm-Ethnicraft Clearance

Plateau – Mist Gold Organic – O 48 Cm-Ethnicraft Clearance
€121.52 Original price was: €121.52.€85.46Current price is: €85.46.
SKU: SKU37b8278bce754f8a8c12f1b21c5bb4e9 Categories: Accessoires De Table, Plats & Plateaux, Table & Cuisine Tag: Ethnicraft Brand: Ethnicraft
Distinctive Et Luxueuse, La Collection De Plateaux Mystic Gold Illumine Instantanément Un Espace Avec Ses Couleurs Ensoleillées, Ses Motifs Modernes Et Ses Éclats D’Or Revigorants. Le Contraste Entre Ses Jantes En Bois Sombre Et Ses Bases En Verre Brillant Met Encore Plus En Évidence Les Teintes Exquises D’Or Qui Prévalent.
Be the first to review “Plateau – Mist Gold Organic – O 48 Cm-Ethnicraft Clearance” Annuler la réponse
Related products
€118.58
€129.71
Sale!
Sale!
€118.58
€102.02
€111.31
Sale!
Sale!
Bureaux & Secrétaires
€122.35
Sale!
Sale!
Sale!
Sale!
€127.78
Sale!

Reviews
There are no reviews yet.